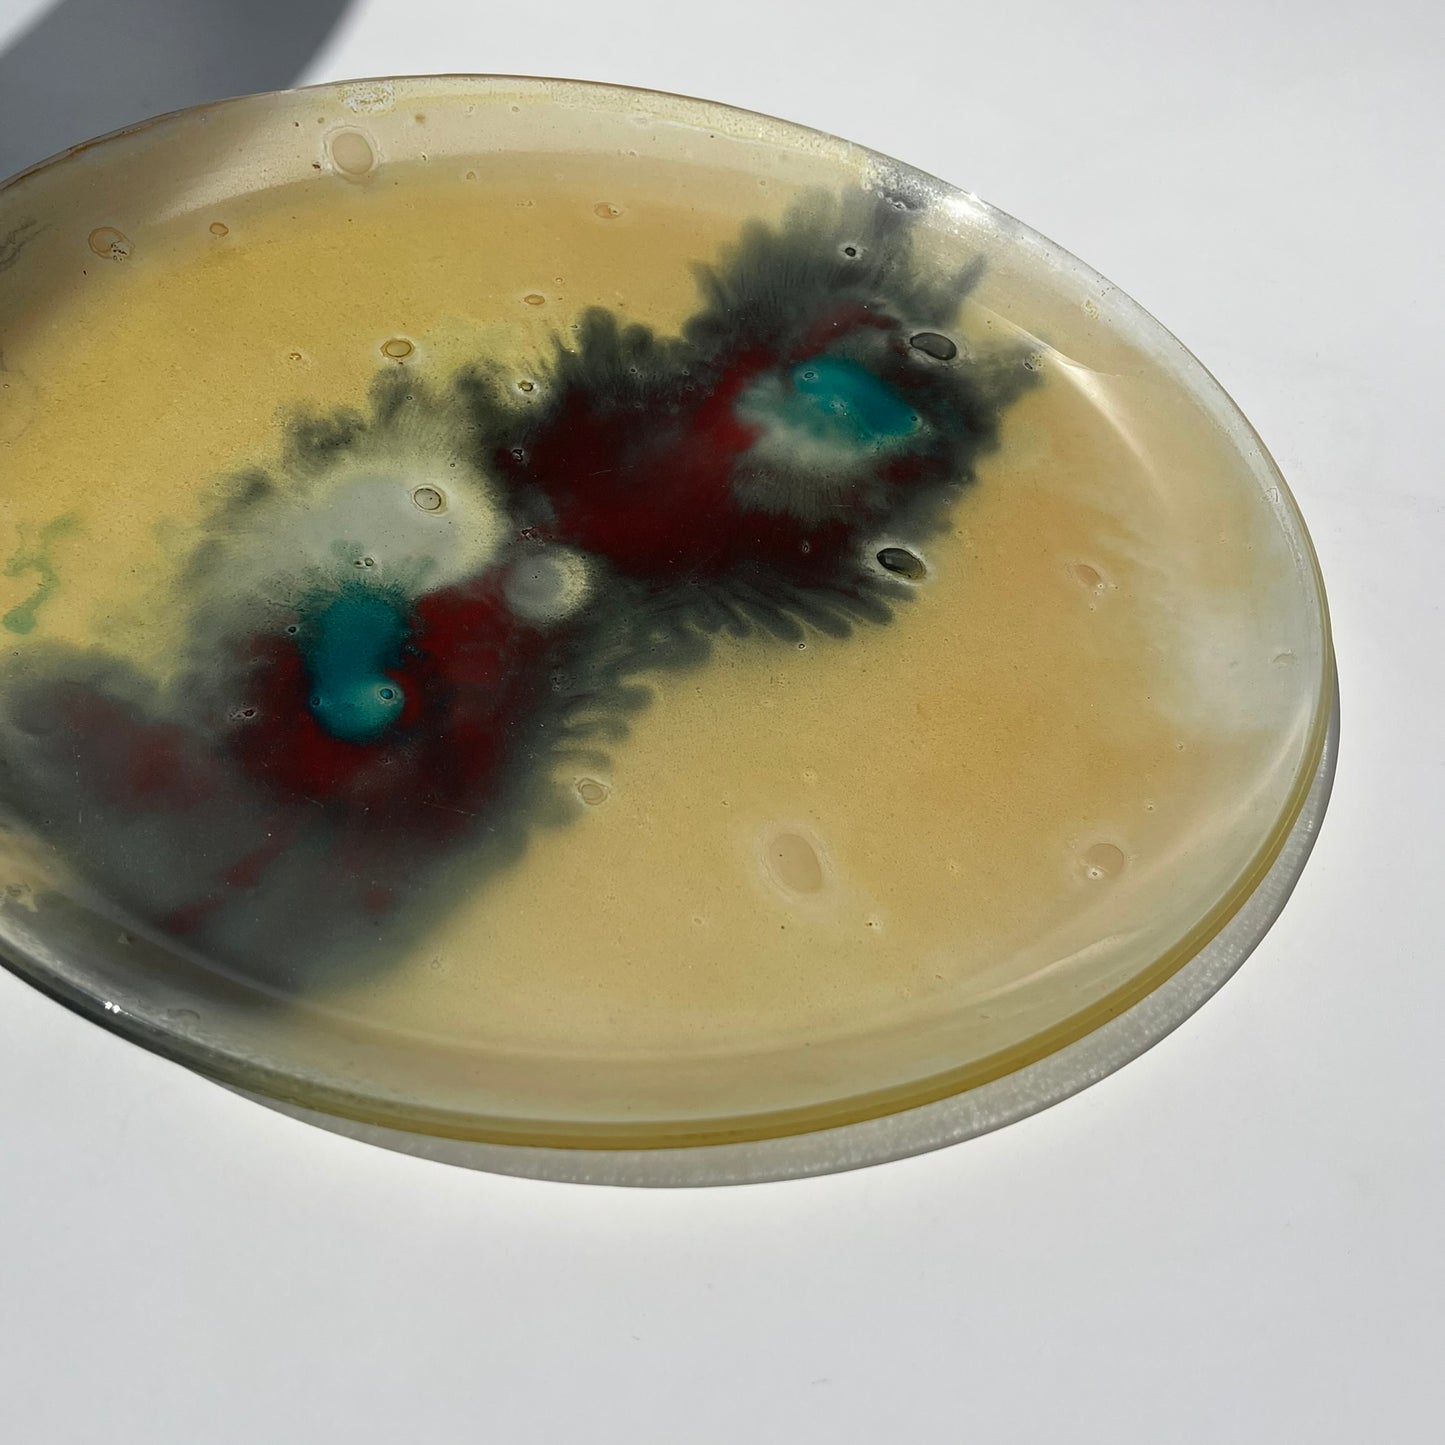

1
/
de
4
Antônio
Prato Tie Dye
Prato Tie Dye
Preço normal
R$ 540,00
Preço normal
Preço promocional
R$ 540,00
Preço unitário
/
por
Não foi possível carregar a disponibilidade de retirada.
Prato para servir em pasta de vidro
Medidas
37cm diâm.
Condição
Peça conservada no estado original
Origem
Desconhecida
Compartilhar